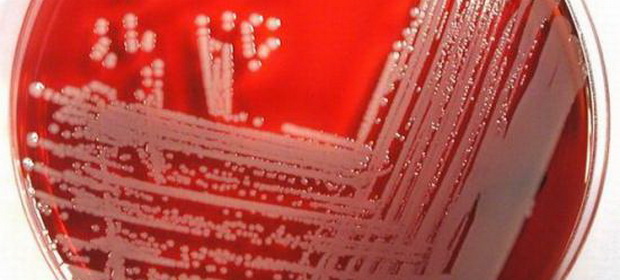

ActiveWatch cere publicarea stenogramei ședinței de Guvern din 29.10.2014

ActiveWatch, în calitatea sa de organizație de drepturile omului ce militează pentru comunicare liberă în interes public, vă solicită, în baza legii 544/2001 privind accesul la informațiile de interes public, să ne puneți la dispoziție stenograma ședinței de Guvern din 29 octombrie 2014 în care a fost discutat și proiectul senatorului Șerban Nicolae de modificare a Codului Penal. Conform comunicărilor oficiale ale Guvernului, actul normativ a primit inițial aviz favorabil, după care Guvernul a revenit și a modificat informarea de presă, anunțând că proiectul a primit “Aviz nefavorabil în forma prezentată”. Guvernul susține că a o “eroare tehnică” a generat această inadvertență.